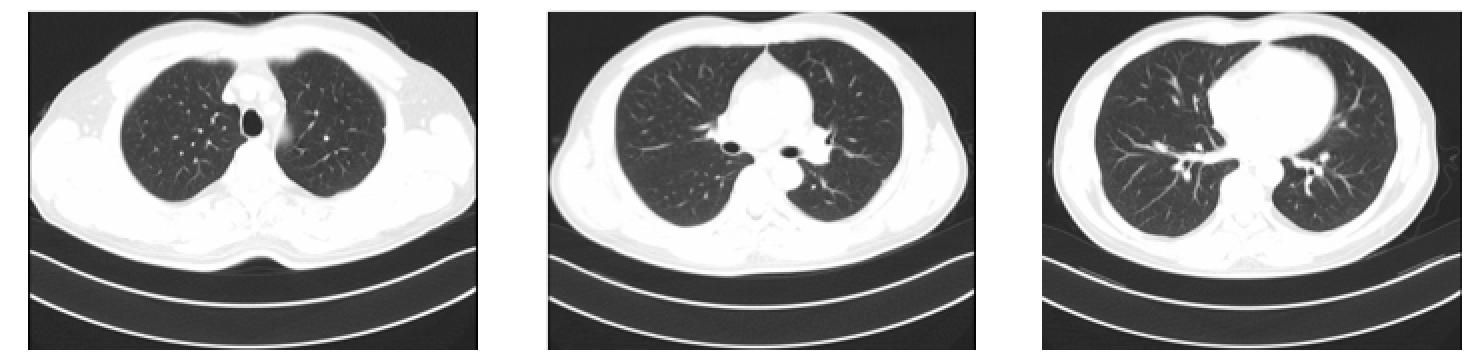
直肠腺癌肺转移最好的治疗方案,得了直肠腺癌不治疗能活几年

来源:肿瘤资讯
【35 under 35】风采展示第二轮已经开始啦!本轮正经名叫“病例实战分析”,不正经名叫“互相伤害”,哈哈哈~100位入围选手每人提交一个有意思的病例,并就病例提出一个问题,形成一个病例库!然后100位入围选手从病例库中任意选择一个非自己提供的病例进行解读并回答问题!最后,我们将呈现病例+别人的点评+病例提供者自己的点评,同步展示!

100位小伙伴已将自己的病例提交,并提出了问题,让我们一起先阅读下精彩病例吧!
患者病史摘要
男,47岁,于2016年12月12日入院。
主诉:大便性状改变伴血便4+月,确诊“直肠腺癌”14天。
现病史:4+月前出现大便性状改变,稀便,伴少量血便,伴排便不尽感,无腹痛腹胀等不适,未予以重视。1月前症状加重,院外行肠镜检查示:距肛门约7-10cm直肠见一肿块新生物。我院病理会诊示:直肠新生物,腺癌(含粘液腺癌成分)。
既往史:无特殊。
查体:T:36.6℃,P:78次/分,R:20次/分,BP:100/65mmHg。
全身浅表淋巴结未扪及肿大。
心肺未见明显异常。
腹部外形正常,全腹软,无压痛及反跳痛,腹部未触及包块。肝脏肋下未触及。脾脏肋下未触及。双肾未触及。双下肢无水肿。
直肠指检:包块距肛门约6CM,质脆,退出指套血染。
实验室检查:
血常规:未见特殊异常
生化:未见特殊异常
肿瘤标志物:CEA 2.23ng/ml,CA19-9 116.10U/ml
肠镜检查
院外肠镜(2016.11.25):
距肛门约7-10cm直肠见已肿块新生物,边界不清,浸及管腔1/2周,表面不光滑、伴有糜烂及溃疡形成,边缘隆起,触之易出血。
病理活检

结论:直肠腺癌(含粘液腺癌成分)。
影像学基线检查
胸部CT

右肺中叶及左肺上叶尖后段少许感染。
全腹CT

直肠中下段肠壁增厚,考虑直肠癌,伴直肠周围间隙、直肠旁间隙、双侧髂血管旁淋巴结增多、增大,请结合临床及其他检查。
左侧肾上腺结节,转移?腺瘤?或其他?左肾前下份轮廓欠光整,慢性炎症改变?左肾小囊肿。
肝右后叶上段钙化灶
直肠MRI

DIS:直肠肿瘤位于:中下段,位于腹膜反折上、下,肿瘤下极距肛下缘约4.8cm。
T:肿瘤中心位于直肠后壁;侵及肠壁(突出浆膜、外膜);直肠系膜受累及(侵出肠壁约1.9cm),距离直肠系膜环周0.5cm。
A(肛管):肿瘤未累及侵犯肛管。
N(淋巴结):直肠系膜区及盆腔多发增大淋巴结,DWI呈高信号,T2WI呈高信号,最大位于左侧髂血管旁,直径约2.7cm。
C(CRM,环周切缘):增大淋巴结距离直肠系膜周边最近距离<1mm,系膜环周筋膜受累。
E(EMVI,壁外血管侵犯):直肠周围静脉丛可疑受侵犯
直肠中下段癌,距肛下缘4.8cm,位于腹膜反折上、下,肛管未受累,直肠系膜区及盆腔多发肿大淋巴结,环周切缘阳性,壁外血管可疑受侵犯。
诊断:
1、直肠腺癌(cT3N+M1,侧方淋巴结+,MRF+)
2、左侧肾上腺结节,转移?腺瘤?或其他?
3、左肾小囊肿
4、右肺中叶及左肺上叶尖后段少许感染
问题:下一步治疗方案如何选择?
A 手术+辅助放化疗
B 新辅助同步放化疗+手术+辅助化疗
C 新辅助化疗+手术+辅助治疗
D 其他
此病例共有1位入围选手点评:36-李清国;病例提供作者为:19-文凤 。详情如下:
点评医生简介:36-李清国

点评内容分享:
下一步治疗应该选择:新辅助放化疗后再评估再手术。
依据:1. 术前直肠肿瘤评估cT3N+M1,侧方淋巴结+,MRF+,按照NCCN指南对于局部进展期直肠癌cT3N+性的患者推荐行术前新辅助放疗。2.该患者MRI检查提示有侧方淋巴结转移。文献报道进展期直肠癌侧方淋巴结转移的发生概率为8.6%~49.0%,差异较大。目前西方国家与日本学者关于侧方淋巴结处理存在较大争议。西方国家学者则主张对T3N+的进展期直肠癌均施行术前新辅助放疗或放化疗,以降低局部复发,并认为放化疗能杀灭侧方转移淋巴结,并且可以避免侧方淋巴结清扫术所带来的高并发症发生率。日本大肠癌研究会主张对T3和T4进展期低位直肠癌常规施行侧方淋巴结清扫以加强局部控制及提高生存率,但日本的JCOG0212多中心研究显示侧方淋巴结清扫术并不能带来5年总体生存率及无复发生存率的改善,但能显著降低患者的局部复发率,尤其是降低侧方区域的局部复发。这其实与新辅助放化疗带来的对局部控制的改善是基本一致的。新辅助放化疗和侧方淋巴结清扫孰优孰劣目前还缺乏头对头的大样本的前瞻性的研究。在我国目前较多的参考西方国家的结直肠癌治疗指南。该患者如新辅助放化疗后侧方淋巴结消退不明显还是需要考虑行侧方淋巴结清扫。3.该患者MRI评估 MRF+,术前MRI评估MRF与术后病理CRM有高度一致性,MRF+的患者直接手术会出现较高的CRM阳性可能,增加局部复发的风险。4.CT提示左肾上腺结节转移不能除外。结直肠癌肾上腺转移较少见,因没有影像学资料及大小的描述,目前难以作出判断。可于术前新辅助放疗过程中观察肾上腺结节大小的变化,如结节大小有变化,可考虑为转移性结节,肾上腺的寡转移结节也可考虑根治性手术切除。如肾上腺结节较大也可考虑术前穿刺病理协助诊断。
另,双肺少许炎症可予以积极抗炎等处理,避免放化疗、手术等过程中机体免疫力下降,炎症加重可能。
--------------------------------------
病例提供作者简介:19-文凤

病例提供作者自评:
自从2013版ESMO直肠癌指南出炉后,以"肛门指诊+直肠腔内超声+高分辨率盆腔MRI"联合一体的综合手段便成为局部进展期直肠癌"(LARC)术前精准分期的检测手段,然后基于肿瘤位置(距肛缘距离)、T分期、N分期、肠壁外血管浸润(EMVI)和直肠系膜筋膜(MRF)等因素来对直肠癌的局部复发风险进行分级,最后根据复发风险程度选择不同的治疗模式[1, 2, 3]。ESMO倡导的这种基于复发危险度的精细个体化治疗模式对于传统意义上的LARC(即分期>cT3或N+)具有更加重要的意义,同时ESMO指南将LARC进一步细分为不同亚组,避免了将所有LARC都进行术前治疗而带来的"过度治疗"问题。目前国际主流治疗LARC的策略—"术前同步放化疗+TME手术+术后辅助化疗"的"三明治式治疗"在临床上受到广泛的欢迎。
来自德国的CAO/ARO/AIO-94临床研究和英国的MRC CR07两个关键的临床试验奠定局部晚期直肠癌术前新辅助放化疗的基础[4, 5]。相对于术后放化疗来说,术前放化疗又具有其临床和生物学上的优点:经过放疗后肿瘤降期退缩,在尽可能提高切除率的同时,肿瘤的退缩可能增加保留肛门括约肌的机会,尤其是对低位直肠肿瘤;同时,术前放化疗可以降低术中播散的概率;且此时肿瘤乏氧细胞少,对放疗较术后放疗敏感;还有一个优点,即没有经过手术的患者小肠未坠入盆腔、蠕动度较术后大,故对小肠的损伤较小。目前欧洲较多的肿瘤中心对T3N1-2M0或T4N0-2M0的患者采取术前新辅助放疗或放化疗。新辅助放疗的方式主要有两种,一种为短程快速大分割放疗,多采用每次5.0 Gy,共25.0 Gy(5次),通常放疗结束后1周内手术。另一种为常规分割,45.0~50.4 Gy,每次1.8 Gy,通常手术在放疗结束后6~8周进行。但是两个在局部控制率和远处转移率上都没有统计学差异[6]。但是常规分割放疗时间更长久,可以与化疗联合作用,且治疗后与手术间隔时间长,可以获得更多的肿瘤退缩时间,显示出较好的近期疗效。故我们病例选择常规分割50.4Gy/28次联合XELOX方案做术前辅助放化疗。
值得提出来的是,患者前期无肾上腺肿瘤的病史,也无肾上腺瘤的相应症状,对于左侧肾上腺结节,考虑到直肠癌最易转移到肝脏及肺上,转移到肾上腺的可能性很小,所以我们采用随访监测的方法,排除直肠癌肾上腺转移。根据前后几次的CT报告可以看出肾上腺上的结节没有变化,故排除直肠癌肾上腺转移的可能。
随着治疗方式的不断出现和治疗组合的不断更新,LARC的处理成为大肠癌领域治疗的重点和难点。因此建立一个多学科团队对LARC进行定期多学科讨论是目前不断提高其治疗疗效、延长患者生存期和改善患者生活质量最有效的策略之一[7, 8]。本案例便是四川大学华西医院肠癌MDT治疗模式下的成功案例。
MDT讨论意见:
B 新辅助同步放化疗+手术+辅助化疗
诱导化疗:2016-12-14第一周期XELOX方案化疗
(卡培他滨早2000mg 晚1500mg po d1-14+奥沙利铂240mg d1 ivgtt q3w)
同步放化疗:
放疗:2017.1.3- 2.14 盆腔放疗,剂量:50.4Gy/28次,
化疗:希罗达 1500mg bid po,w1-5,28天
疗效评估(同步放化疗结束时,2017.2.14):SD

直肠中下段肠壁增厚,考虑直肠癌,伴直肠周围间隙、直肠旁间隙、双侧髂血管旁淋巴结增多、增大,与2016-12-2日旧片比较,左侧髂血管旁淋巴结略缩小,其余未见明显变化,请结合临床及其他检查。
左侧肾上腺结节,转移?腺瘤?或其他?与上述旧片比较未见明显变化。
左肾前下份轮廓欠光整,慢性炎症改变?左肾小囊肿。
肝右后叶上段钙化灶。
前列腺钙化灶。
肿瘤标志物:CEA 1.29 ng/ml,CA19-9 21.39 U/ml.
巩固化疗:2周期化疗,XELOX方案(2017.2.28, 2017.4.7)
疗效评估(2017.4.26):PR?
直肠指检:包块距肛门约6CM,质脆,退出指套无血染。
肿瘤标志物:CEA 1.51ng/ml,CA19-9 13.53U/ml
胸部CT

右肺中叶及左肺上叶尖后段纤维条索影。
左肺下叶外基底段小结节影:炎性结节?请随访。
全腹CT

直肠中下段肠壁增厚,考虑直肠癌,伴直肠周围间隙、直肠旁间隙、双侧髂血管旁淋巴结增多、增大,与2017-02-14日旧片比较,直肠壁增厚较前减轻,其余未见明显变化,请结合临床及其他检查。
左侧肾上腺结节,转移?腺瘤?或其他?与上述旧片比较未见明显变化。
左肾前下份轮廓欠光整,慢性炎症改变?左肾小囊肿。
肝右后叶上段钙化灶。
前列腺钙化灶。
直肠MRI


DIS:直肠肿瘤位于:中下段,位于腹膜反折上、下,肿瘤下极距肛下缘约4.5cm。
T:肿瘤中心位于直肠后壁;侵及肠壁(突出浆膜、外膜);直肠系膜受累及(侵出肠壁约1.9cm),距离直肠系膜环周0.5cm。
A(肛管):肿瘤未累及侵犯肛管。
N(淋巴结):直肠系膜区及盆腔多发增大淋巴结,DWI呈高信号,T2WI呈高信号,最大位于左侧髂血管旁,直径约4.0cm。
C(CRM,环周切缘):增大淋巴结距离直肠系膜周边最近距离<1mm,系膜环周筋膜受累。
E(EMVI,壁外血管侵犯):直肠周围静脉丛可疑受侵犯。
直肠中下段癌,距肛下缘4.5cm,位于腹膜反折上、下,肛管未受累,直肠系膜区及盆腔多发肿大淋巴结,环周切缘阳性,壁外血管可疑受侵犯。
肝右叶小囊肿。
双肾多个小囊肿。
DWI

下一步治疗:
A 手术+辅助化疗
B 继续原方案化疗
C 换方案化疗
D 其他
手术方式:
A TME
B TME+侧方淋巴结清扫
C 其他
手术 (2017.5.2) (放疗结束11周)
腹腔镜下直肠癌TME超低位前切除,结直肠吻合术,双侧侧方淋巴结清扫术,盆丛神经部分切除术,小肠造瘘术,肠粘连松解术,开腹恶性肿瘤特殊治疗。
术中见:
中段直肠腹膜反折处可见一质硬肿块,主体位于腹膜反折下方,周围肠壁顺应性差,周围筋膜组织水肿增厚明显,左侧髂内血管旁可见一2cm大小肿大淋巴结,质硬,向内侵犯盆丛神经上部,向内侵犯髂内血管膀胱上动脉分支以下多支血管,左侧闭孔内可见一3cm大小质硬淋巴结,向外向内亦与髂内血管分支致密粘连,向外与闭孔神经致密粘连,可疑累及闭孔神经包膜,右侧髂内血管分叉下方可见一1.5cm大小质硬肿大淋巴结,向内累及右内盆丛神经上部,向下与髂内膀胱下动脉分支致密粘连。
术后病理:

肿瘤对放化疗反应:
术前是否接受新辅助放疗/放化疗: 是;
接受新辅助治疗者:完全缓解(TRG0);注:镜下见广泛粘液糊至肠周脂肪内。
淋巴结:受检淋巴结数:16枚;阳性淋巴结数:0枚。注:7枚淋巴结内见粘液湖残留。
术后复查:
肿瘤标志物:CEA 1.86ng/ml,CA19-9 6.29U/ml
胸部CT
肺中叶及左肺上叶少许纤维条索。
左肺下叶外基底段小结节影:炎性结节?请随访。
上述表现比较2017-04-26CT无明显变化。
腹部CT

“直肠癌术后”,未见明显复发征象,请结合临床及其他检查。
腹盆腔少许积液,盆底筋膜增厚。双侧盆壁内侧斑片状及片状不规则低密度影,未见明显强化,积液可能,请随访。
左侧肾上腺结节,转移?腺瘤?或其他?与2017-04-26旧片比较未见明显变化。
左肾前下份轮廓欠光整,慢性炎症改变?
左肾小囊肿。
肝右后叶上段钙化灶。
前列腺钙化灶。
术后治疗:2017.6 行辅助化疗,XELOX方案
-------------------------------------
以上为【35 under 35】的观点,您怎么看?欢迎广大肿瘤医生在下方留言发表您的观点!
参考文献
以上所有点评参考文献略。
版权声明版权属肿瘤资讯所有。欢迎个人转发分享,其他任何媒体、网站如需转载或引用本网版权所有内容,须获得授权,且在醒目位置处注明“转自:良医汇-肿瘤医生APP”。